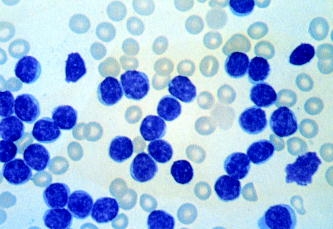
Lenfosit

Lenfosit

Lenfosit bir çeşit akyuvar türüdür. Kan içersinde dolaşan lökositlerin yani akyuvarların yarıya yakınını lenfositler oluşturmaktadır. Lenfosit testi de bedenimizdeki lenfositlerin sayısını ve lökositlerin % 20 ile % 55’i arasında bir oranda bulunurlar. Kan içinde dolaşan lenfositler, alyuvarlardan şekil olarak daha büyüktür. Lenfositler, “büyük granüler lenfositler” ve “küçük lenfositler” olarak iki bölüme ayrılır. Büyük granüler lenfositler, doğal öldürücü hücreler olarak da ifade edilir ve doğal bağışıklığın bir bölümü olarak da sayılırlar. Konağın, tümörlere ve virüslerle enfekte olmuş hücrelere karşı savunmasında fonksiyonları vardır.
Ufak lenfositler ise T lenfositleri ve B lenfositlerinden meydana gelmektedir. T-Lenfositleri kanda dolaşan bütün lenfositlerin ortalama % 80′ini oluşturmaktadırlar. Hücresel bağışıklıktan ve B lenfositlerin aktivitelerinden sorumludurlar. B-Lenfositleri ise antikorların oluşumunda etkili olmakla birlikte humoral bağışıklıktan da sorumudurlar. Kanda bulunan lenfosit sayısının normal derecesinin üzerine çıkmasına lenfositoz denir.
Henüz yorum yapılmamış.